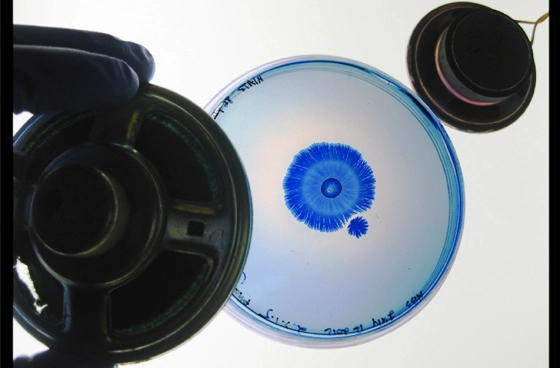

A biologia está intrínseca em nós, e assim como a arte, ela faz parte da nossa vida. A artista Nurit Bar-Shai, que utiliza a interdisciplinaridade em seus projetos, sabe muito bem disso.
Apesar de seus trabalhos anteriores terem sido na área da arte e da tecnologia, ela decidiu inovar integrando a biologia e criando o projeto Objectivity, que utiliza colônias da bactéria Paenibacillus vortex para criar sua obra.
Paenibacillus vortex
A Paenibacillus vortex é uma bactéria com grande interação com o meio que vive, ou seja, recebe influências do ambiente ao seu redor e isso determina a forma como cresce, como se reproduz e como modifica a forma das suas colônias. É conhecida também, por sua boa interação social e são encontradas no solo, larvas de inseto e em muitos outros lugares. Seu nome se refere ao formato de vortex (espiralado) característico de suas colônias, que ajudam na alimentação e na proteção destes seres.
Utilizando espécies de ‘tweet químico’, ou seja, uma comunicação química, as informações são passadas entre os indivíduos da colônia que acabam adotando diferentes formas, sendo possível observa-las com o uso de pigmento.
The Soundscapes e Sound to Shape
The Soudscapes series, retrata uma fase do estudo da Nurit Bar-Shai que verifica como a colônia reage as ondas sonoras do ambiente, verificando suas formas e arquitetura.
Sound to Shape faz parte do The Soundscape series e é uma instalação e uma perfomance com colônias de Paenibacillus vortex, em que as bactérias são expostas a diferentes sons de alto falantes onde as ondas sonoras interagem com o ágar das placas de Petri e com as bactérias e fazem com que elas assumam diferentes formas e estruturas das colônias, dependendo do comprimento de onda do som que incide sobre elas.
O mundo não é mais um lugar em que as coisas são separadas por áreas. Parar criarmos coisas novas, é necessário agregarmos a interdisciplinaridade em nossas vidas!
Referências

Estudante de design de Moda da UFG, mas com um pé nas exatas e nas biológicas. Sou ex aluna de IF, lugar em que cresci, amei e me desenvolvi! Amo me conectar, me mostrar, sorrir, viver e ser. Apaixonada por coisas fofinhas, coloridas e artesanato. Meu lado dark fica só na música e nos animes! Não tenha medo de falar comigo, amo histórias e aprender coisas novas ♥

![2012 Bar-Shai Objectivity [tentative] Bar-Shai: Objectivity [tentative]](https://biostudiodesign.com.br/wp-content/uploads/elementor/thumbs/2012_Bar-Shai_Objectivity-osrax1id2n7xpwj6nlmuwl4e8wd1qe5459x9s1t3m0.jpg)